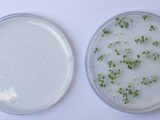

EVALUARÁN BIODIVERSIDAD DEL SUELO CON MICROSCOPIO QUE USA PIEZAS EN 3D
14 enero, 2026Foto: UNAM. El aparato es liviano y enfoca a nivel de micras.
Fuente: UNAM
Personas trabajadoras del campo podrán evaluar la biodiversidad del suelo con el uso de microscopios portátiles de bajo costo, que pueden llevarse en una mochila, adaptarse a un teléfono celular con cámara, y lograr aumentos para explorar una amplia gama de animales microscópicos.
Se trata de una iniciativa de la UNAM encabezada por personal experto del Programa Universitario de Estudios Interdisciplinarios del Suelo (PUEIS) y el Instituto de Ciencias Aplicadas y Tecnología (ICAT).
Las primeras pruebas se llevarán a cabo en Xochimilco, al sur de la Ciudad de México.
Esta iniciativa se inscribe dentro del programa Doctores de los Suelos, impulsado por la FAO a nivel global y del cual el PUEIS es el encargado en México. El proyecto busca capacitar a los agricultores para que aprendan a evaluar la salud del suelo, y promover un manejo sostenible en la agricultura, explicó la coordinadora del PUEIS e investigadora del Instituto de Geología, Blanca Prado Pano.
Realizadas las observaciones, las y los campesinos aplicarán un método desarrollado en esta casa de estudios para evaluar la biodiversidad, el cual será validado a nivel internacional por la Organización de las Naciones Unidas para la Alimentación y la Agricultura (FAO) en México, Colombia y Burkina Faso (África Occidental).
Elaboramos el método con colegas biólogos de varias entidades dentro y fuera de la UNAM. “Cuando lo propusimos a la FAO dijeron que tenía el gran inconveniente de que necesitaba un microscopio y lo rechazaron. Entonces buscamos a Martha Rosete y a José Ocampo, quienes desarrollaron el microscopio. Lo valioso de este invento es que hará posible que los agricultores pasen de un conocimiento teórico a conocer a los organismos que tiene su suelo”.
Microscopios en 3D
La iniciativa de diseñar un microscopio portátil y de bajo costo con impacto social es de José Ocampo López Escalera, estudiante del doctorado en Ciencias en Ecología y Desarrollo Sustentable de El Colegio de la Frontera Sur (ECOSUR), quien tiene como codirectora de tesis a Martha Rosete Aguilar, investigadora del ICAT, física y doctora en óptica.
Martha Rosete destacó: Generalmente los microscopios que se usan en los laboratorios requieren una preparación particular, porque hay que enfocar y controlar iluminación, entre otros pasos.
Además, son equipos pesados y caros que no se pueden meter en una bolsa y requieren conectarse para tener luz. Con su tesis de doctorado, José Ocampo logró un equipo pequeño, de aproximadamente 20 x 10 x 10 centímetros; es una cajita liviana con la posibilidad de enfocar y desplazarse a nivel de micras.
El reto parecía complicado, pero logramos construir un dispositivo con piezas accesibles, varias impresas en 3D, lo que facilita que se replique en otros lados, comentó José Ocampo.
El instrumento también tiene baleros, tornillos y una pila recargable con un cargador de teléfono celular convencional, utiliza luz LED y cuenta con un lente sencillo e intercambiable (originalmente de cámaras de vigilancia) para observar diferentes niveles de amplificación.
Comenzaremos la construcción de 15 aparatos para que se efectúen pruebas de validación. Contamos con impresoras 3D en el ICAT, en el Instituto de Física y en ECOSUR.
De acuerdo con el experto, se inició con el registro de diseño industrial para proteger la autoría del dispositivo. “Pero tenemos la idea de publicar cómo se construye el microscopio para que sea de utilidad en otros sitios”.
Práctica accesible
La académica del PUEIS, Carolina Avilés Junco, compartió que el método para evaluar biodiversidad, se desarrolló con académicos de diferentes dependencias de la UNAM, como Francisco Armendáriz Toledano y su equipo del Instituto de Biología; José Guadalupe Palacios Vargas e Isaac Romero Acevedo Rojas, de la Facultad de Ciencias; y Gabriela Castaño Meneses, de la Unidad Multidisciplinaria de Docencia e Investigación de la Escuela Nacional de Estudios Superiores, Unidad Juriquilla.
De una institución diferente, Teresita de Jesús Santiago Vera, del Centro de Investigaciones y Estudios Superiores en Antropología Social (CIESAS), Unidad Sur.
El grupo de personas académicas propuso una práctica accesible para los productores, que se pueda replicar fácilmente y no implique demasiado tiempo.
Consiste en efectuar un muestreo representativo de una parcela, obtener porciones de suelo, separar a los organismos más grandes y clasificarlos. El método incluye una clave de clasificación y una forma de asociar a cada grupo con funciones edáficas específicas.
Existen aquellos encargados de descomponer materia orgánica, otros con un papel importante en la regulación de poblaciones de organismos o en el control de plagas. Unos más generan porosidad y participan en garantizar los flujos de agua y aire dentro del suelo. El objetivo, es que al verlos puedan decir de qué tipo son y a qué grupo pertenecen.
De esta manera sabrán si el suelo es funcional y evaluarán el impacto de sus prácticas agrícolas, partiendo de la premisa de que mayor biodiversidad de actividad significa tener uno más saludable y funcional.